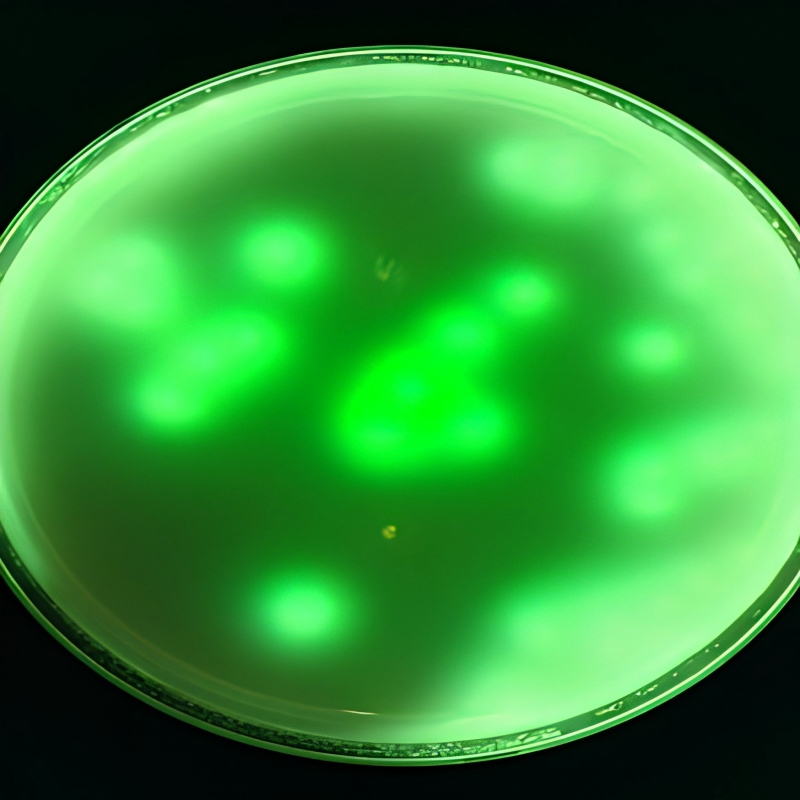

This device utilizes autofluorescence imaging technology to assist healthcare professionals in observing wound conditions in a non-contact and real-time manner.
Vivolight MS9
The Vivolight MS9 utilizes autofluorescence imaging technology to provide enhanced visualization of skin and wound conditions, supporting clinical observation and improving workflow efficiency.

Clinical Application

Dermatoscopy
✔ Enhances visualization of subsurface skin structures.

Thermal lmaging
Wound Management
Leave A Message
Scan to WhatsApp :